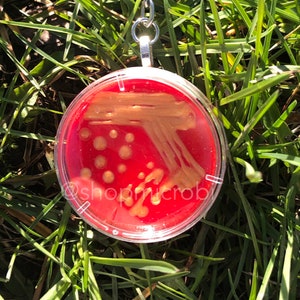

Etsy uses cookies and similar technologies to give you a better experience, enabling things like:
- basic site functions
- ensuring secure, safe transactions
- secure account login
- remembering account, browser, and regional preferences
- remembering privacy and security settings
- analysing site traffic and usage
- personalized search, content, and recommendations
- helping sellers understand their audience
- showing relevant, targeted ads on and off Etsy
Detailed information can be found in Etsy’s Cookies & Similar Technologies Policy and our Privacy Policy.
Personalized Advertising
To enable personalized advertising (like interest-based ads), we may share your data with our marketing and advertising partners using cookies and other technologies. Those partners may have their own information they’ve collected about you. Turning off the personalized advertising setting won’t stop you from seeing Etsy ads, but it may make the ads you see less relevant or more repetitive.
Personalized advertising may be considered a “sale” or “sharing” of information under California and other state privacy laws, and you may have a right to opt out. Turning off personalized advertising allows you to exercise your right to opt out. Learn more in our Privacy Policy., Help Center, and Cookies & Similar Technologies Policy.